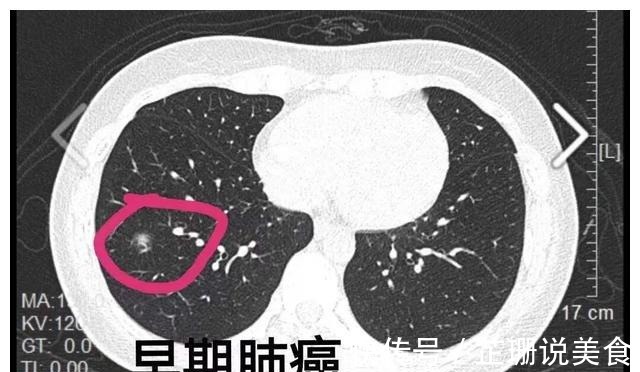
王教授|北大人民医院刘医生父亲查出了肺癌,希望放弃治疗,我没同意

王教授|北大人民医院刘医生父亲查出了肺癌,希望放弃治疗,我没同意( 二 )

文章插图
在这场癌症和医学的较量下,正是有了亲情的陪伴,癌症才能输得如此彻底,希望刘医生的经历能帮助正在经历癌症折磨的患者,愿世界永无病痛。肺癌老父亲为什么能治好?刘医生父亲能康复,不仅仅是因为王教授的手艺好,更关键的是因为刘父的肺癌并没有进展到后期。
文章插图
早期肺癌只要经过手术治疗和化疗就能完全康复,5年生存率非常高,部分患者可以存活20年以上不复发。因此,医生提醒,有以下生活习惯的人群需要注意,建议经常体检以防肺部癌变,不要像刘父那样患癌后才后悔。1,吸烟很凶的人据统计,肺癌患者中有90%的人拥有10年以上的烟龄,香烟中有尼古丁、焦油和两百多种毒素,它们能堵塞患者的肺泡,影响人体正常的气体交换,还能让肺部变黑,使正常的肺组织完全坏死,可以说抽烟者就是肺癌的预备军。
文章插图
除此以外,抽烟者祸害的不仅是自己,二手烟的危害比直接抽烟更严重,抽烟者不但在自杀,也在危害家人、孩子的生命。2,长期在粉尘漫布的工厂工作刘医生的父亲为什么突然患上肺癌?主刀医生王教授切开刘父的肺叶后惊讶地发现,他肺部的淋巴结增生非常多,肺部血管很难找到与精准下刀。而它肺部淋巴结增生的原因,就是粉尘吸入过多导致肺泡难以扩张,最终促使淋巴液分泌增加,淋巴功能亢进。久而久之就演变成了肺小细胞癌症。刘医生解释,他的父亲曾在某建筑公司做过机械工,平时做的工作是切割车床、电焊、电器切,因此吸入的颗粒物数量过多导致了肺部发生病变。
文章插图
据临床统计,我国有许多因工作患肺癌的人,例如“硅肺”、“石绵肺”等等,时间一长还有可能直接导致肺纤维化。所以从事伴随颗粒物吸入的工作者,应当尽早进行肺部检查,将患癌的可能性扼杀在摇篮中。
- 胰腺癌|胰腺癌被称为癌症之王,眼睛皮肤出现一个症状,提示癌症已是晚期
- 王成|晨跑半小时与晚上散步一小时,有什么区别哪个更健康
- 癌症|此物被称是“抗癌王”,含硒量还高,每天吃一点,癌症躲着你
- 浓茶色|胰腺癌是癌症之王,眼睛出现一个征兆的时候,尽早去医院体检一下
- 原因|杭州中医肿瘤科医院王惠兰主任详解肺癌诱因
- 本文转自:深圳新闻网读特客户端·深圳新闻网2022年1月21日讯(记者王志明)近日|玩胜体能助力“战疫”为防疫志愿者健康“护航”
- 猕猴桃的营养价值 被称为水果之王
- 王晓莲:融汇中西医诊疗皮肤病|首都国医名师 | 皮肤科
- 黄金时间|孩子学习困难并非小事!北京专家贾军朴教授,助力儿童健康成长!
- 王卫明|形成22大类1100多个品类,覆盖卫生健康各环节 医疗装备产业前景可期(新视点)
